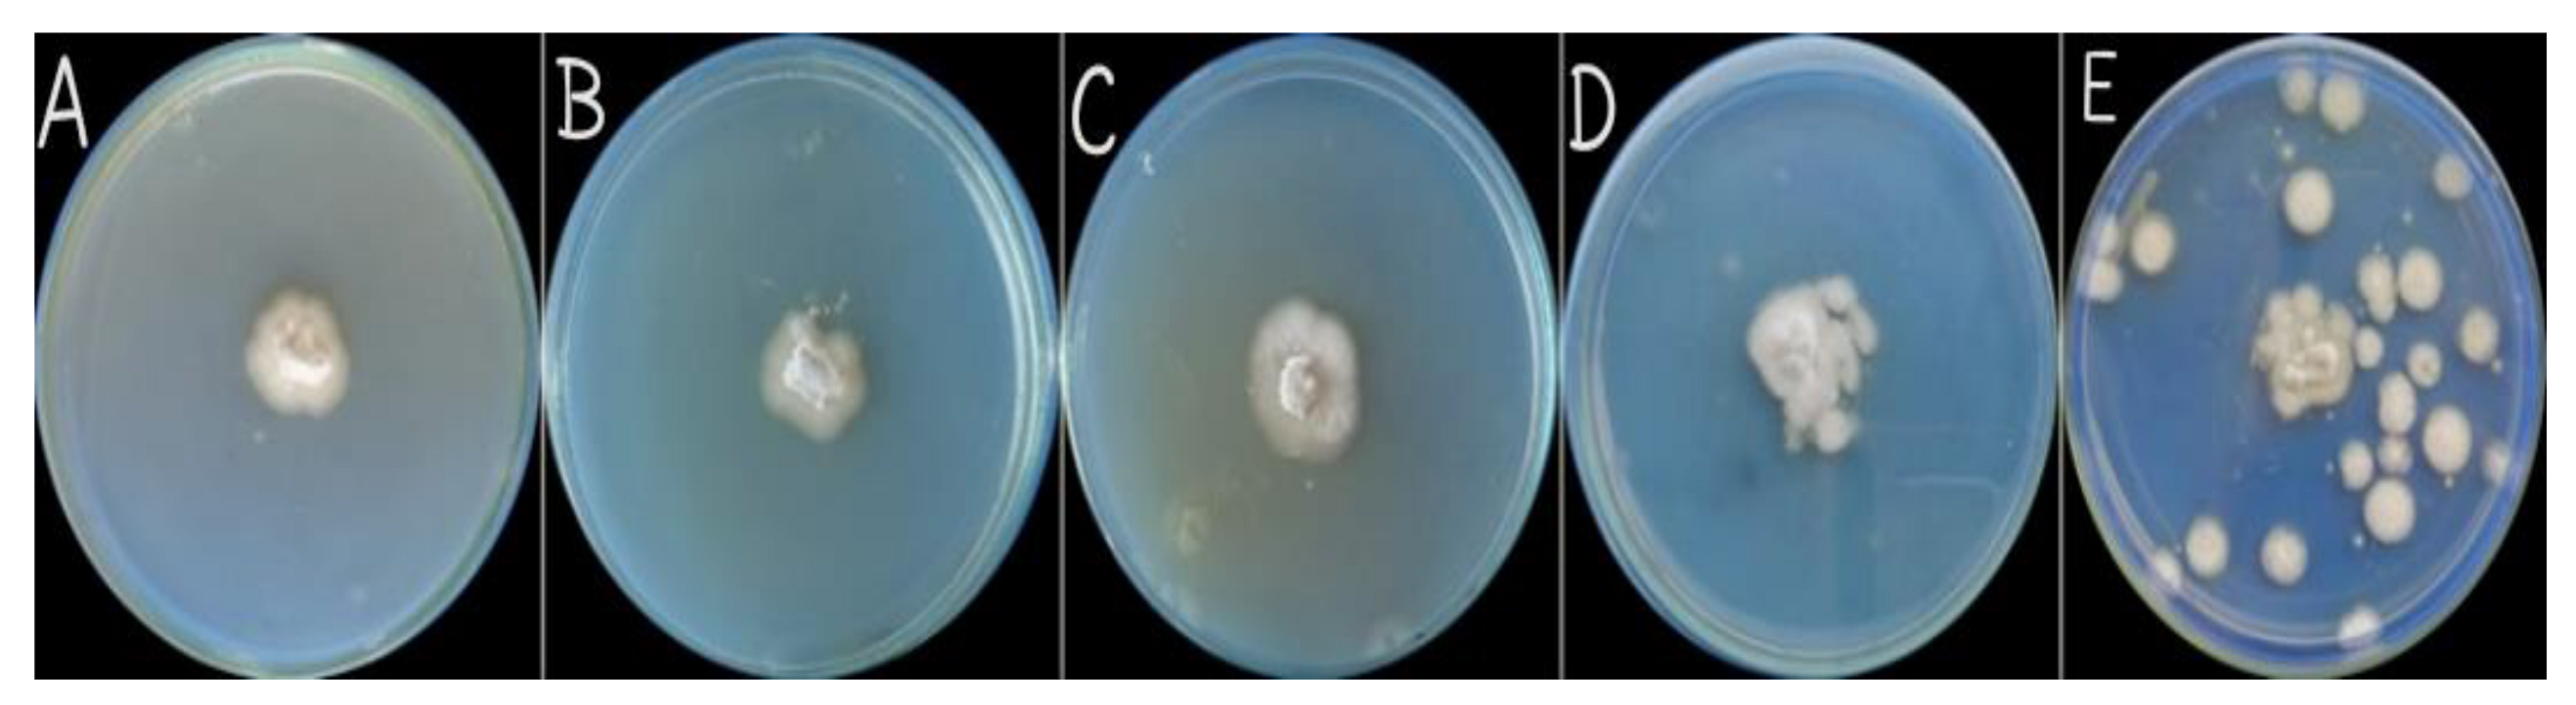
Micromachines 14 01285 g008 Micromachines 14 01285 g008

Synthesis and Characterization of Zinc Oxide Nanoparticles at Different pH Values from Clinopodium vulgare L. and Their Assessment as an Antimicrobial Agent and Biomedical Application
Abstract
1. Introduction
2. Materials and Methods
2.1. Extract Preparation
2.2. Synthesis of ZnONPs
2.3. Characterization of ZnO NPs
2.4. Antibacterial Assay
2.5. Antifungal Activity
2.6. Antileishmanial Activity
2.7. Statistics
3. Results and Discussions
3.1. Biogenic Synthesis of ZnONPs
3.2. Characterization of ZnO NPs
3.2.1. UV-Spectra Analysis
3.2.2. X-ray Diffraction Analysis
3.2.3. SEM Analysis
3.2.4. FTIR Spectroscopy Analysis
3.3. Antibacterial Assay
3.4. Antifungal Assay
3.5. Antileishmanial Activity
4. Conclusions
Author Contributions
Funding
Data Availability Statement
Conflicts of Interest
References
- Wouters, R.D.; Muraro, P.C.L.; Druzian, D.M.; Viana, A.R.; de Oliveira Pinto, E.; da Silva, J.K.L.; Vizzotto, B.S.; Ruiz, Y.P.M.; Galembeck, A.; Pavoski, G.; et al. Zinc oxide nanoparticles: Biosynthesis, characterization, biological activity and photocatalytic degradation for tartrazine yellow dye. J. Mol. Liq. 2023, 371, 121090. [Google Scholar] [CrossRef]
- Popa, M.L.; Preda, M.D.; Neacșu, I.A.; Grumezescu, A.M.; Ginghină, O. Traditional vs. Microfluidic Synthesis of ZnO Nanoparticles. Int. J. Mol. Sci. 2023, 24, 1875. [Google Scholar] [CrossRef] [PubMed]
- Kumar, S.; Ahlawat, W.; Kumar, R.; Dilbaghi, N. Graphene, carbon nanotubes, zinc oxide and gold as elite nanomaterials for fabrication of biosensors for healthcare. Biosens. Bioelectron. 2015, 70, 498–503. [Google Scholar] [CrossRef]
- Vijayalakshmi, K.; Sivaraj, D. Synergistic antibacterial activity of barium doped TiO2 nanoclusters synthesized by microwave processing. RSC Adv. 2016, 12, 9663–9671. [Google Scholar] [CrossRef]
- Dhiman, V.; Kondal, N.; Choudhary, P. Bryophyllum pinnatum leaf extract mediated ZnO nanoparticles with prodigious potential for solar driven photocatalytic degradation of industrial contaminants. Environ. Res. 2023, 216, 114751. [Google Scholar] [CrossRef]
- Singh, N.; Joshi, E.; Sasode, D.S.; Chouhan, N. Application of Nanotechnology in Agriculture. Biot. Res. Today 2020, 5, 163–165. [Google Scholar]
- Kamal, A.; Saba, M.; Farooq, M. Biocompatible formulations based on mycosynthesized iron oxide nanoparticles: Fabrication, characterization, and biological investigation. J. Basic Microbiol. 2023, 2, 156–167. [Google Scholar] [CrossRef]
- Soni, N.; Prakash, S. Factors affecting the geometry of silver nanoparticles synthesis in Chrysosporium tropicum and Fusarium oxysporum. Am. J. Nanotechnol 2011, 1, 112–121. [Google Scholar]
- Tripathy, A.; Raichur, A.M.; Chandrasekaran, N.; Prathna, T.C. Process variables in biomimetic synthesis of silver nanoparticles by aqueous extract of Azadirachta indica (Neem) leaves. J. Nano Res. 2010, 1, 237–246. [Google Scholar] [CrossRef]
- Suresh, P.; Doss, A.; Praveen Pole, R.P.; Devika, M. Green synthesis, characterization and antioxidant activity of bimetallic (Ag-ZnO) nanoparticles using Capparis zeylanica leaf extract. Biomass Convers. Biorefin. 2023, 11, 1–9. [Google Scholar] [CrossRef]
- Badisa, R.B.; Darling-Reed, S.F.; Joseph, P.; Cooperwood, J.S.; Latinwo, L.M.; Goodman, C.B. Selective cytotoxic activities of two novel synthetic drugs on human breast carcinoma MCF-7 cells. Anticancer Res. 2009, 29, 2993–2996. [Google Scholar] [PubMed]
- Senapati, M.H.; Bahramsoltani, R.; Abbasabadi, Z.; Rahimi, R. A omprehensive review on phytochemical and pharmacological aspects of Elaeagnus angustifolia L. J. Pharm. Pharm. 2004, 11, 1467–1480. [Google Scholar]
- Aljabali, A.A.; Akkam, Y.; Al Zoubi, M.S.; Al-Batayneh, K.M.; Al-Trad, B.; Abo Alrob, O.; Alkilany, A.M.; Benamara, M.; Evans, D.J. Synthesis of gold nanoparticles using leaf extract of Ziziphus zizyphus and their antimicrobial activity. Nanomaterials 2018, 8, 174. [Google Scholar] [CrossRef]
- Abbasi, S. Photocatalytic activity study of coated anatase-rutile titania nanoparticles with nanocrystalline tin dioxide based on the statistical analysis. Environ. Monit. Assess. 2019, 191, 206. [Google Scholar] [CrossRef] [PubMed]
- Jain, D.; Bhojiya, A.A.; Singh, H.; Daima, H.K.; Singh, M.; Mohanty, S.R.; Stephen, B.J.; Singh, A. Microbial fabrication of zinc oxide nanoparticles and evaluation of their antimicrobial and photocatalytic properties. Front. Chem. 2020, 8, 778. [Google Scholar] [CrossRef]
- Ahmad, A.; Syed, F.; Imran, M.; Khan, A.U.; Tahir, K.; Khan, Z.U.H.; Yuan, Q. Photosynthesis and antileishmanial activity of gold nanoparticles by Maytenus Royleanus. J. Food Biochem. 2016, 40, 420–427. [Google Scholar] [CrossRef]
- Ibrahim, N.A.; Nada, A.A.; Hassabo, A.G.; Eid, B.M.; Noor El-Deen, A.M.; Abou-Zeid, N.Y. Effect of different capping agents on physicochemical and antimicrobial properties of ZnO nanoparticles. Chem. Pap. 2017, 71, 1365–1375. [Google Scholar] [CrossRef]
- Dragišić Maksimović, J.; Bogdanović, J.; Maksimović, V.; Nikolic, M. Silicon modulates the metabolism and utilization of phenolic compounds in cucumber (Cucumis sativus L.) grown at excess manganese. J. Plant Nutr. Soil Sci. 2007, 170, 739–744. [Google Scholar] [CrossRef]
- Abel, S.; Tesfaye, J.L.; Shanmugam, R.; Dwarampudi, L.P.; Lamessa, G.; Nagaprasad, N.; Benti, M.; Krishnaraj, R. Green synthesis and characterizations of zinc oxide (ZnO) nanoparticles using aqueous leaf extracts of coffee (Coffea arabica) and its application in environmental toxicity reduction. J. Nanomater. 2021, 2021, 3413350. [Google Scholar] [CrossRef]
- Alyamani, A.A.; Albukhaty, S.; Aloufi, S.; AlMalki, F.A.; Al-Karagoly, H.; Sulaiman, G.M. Green fabrication of zinc oxide nanoparticles using phlomis leaf extract: Characterization and in vitro evaluation of cytotoxicity and antibacterial properties. Molecules 2021, 26, 6140. [Google Scholar] [CrossRef]
- Janaki, A.C.; Sailatha, E.; Gunasekaran, S. Synthesis, characteristics and antimicrobial activity of ZnO nanoparticles. Spectrochim. Acta Part A Mol. Biomol. Spectrosc. 2015, 144, 17–22. [Google Scholar] [CrossRef] [PubMed]
- Abbasi, S.; Ekrami-Kakhki, M.S.; Tahari, M. The influence of ZnO nanoparticles amount on the optimisation of photo degradation of methyl orange using decorated MWCNTs. Prog. Ind. Ecol. Int. J. 2019, 13, 3–15. [Google Scholar] [CrossRef]
- Jan, H.; Shah, M.; Usman, H.; Khan, M.A.; Zia, M.; Hano, C.; Abbasi, B.H. Biogenic synthesis and characterization of antimicrobial and antiparasitic zinc oxide (ZnO) nanoparticles using aqueous extracts of the Himalayan Columbine (Aquilegia pubiflora). Front. Mater. 2020, 7, 249. [Google Scholar] [CrossRef]
- Gur, T.; Meydan, I.; Seckin, H.; Bekmezci, M.; Sen, F. Green synthesis, characterization and bioactivity of biogenic zinc oxide nanoparticles. Environ. Res. 2022, 204, 111897. [Google Scholar] [CrossRef] [PubMed]
- Gonçalves, R.A.; Toledo, R.P.; Joshi, N.; Berengue, O.M. Green synthesis and applications of ZnO and TiO2 nanostructures. Molecules 2021, 26, 2236. [Google Scholar] [CrossRef]
- Balraj, B.; Senthilkumar, N.; Siva, C.; Krithikadevi, R.; Julie, A.; Potheher, I.V.; Arulmozhi, M. Synthesis and characterization of zinc oxide nanoparticles using marine Streptomyces sp. with its investigations on anticancer and antibacterial activity. Res. Chem. Intermed. 2017, 43, 2367–2376. [Google Scholar] [CrossRef]
- Suresh, J.; Pradheesh, G.; Alexramani, V.; Sundrarajan, M.; Hong, S.I. Green synthesis and characterization of zinc oxide nanoparticle using insulin plant (Costus pictus D. Don) and investigation of its antimicrobial as well as anticancer activities. Adv. Nat. Sci. Nanosci. Nanotechnol. 2018, 9, 015008. [Google Scholar] [CrossRef]
- Kalpana, V.N.; Devi Rajeswari, V. A review on green synthesis, biomedical applications, and toxicity studies of ZnO NPs. Bioinorg. Chem. Appl. 2018, 2018, 3569758. [Google Scholar] [CrossRef]
- Abbasi, B.A.; Iqbal, J.; Ahmad, R.; Zia, L.; Kanwal, S.; Mahmood, T.; Wang, C.; Chen, J.T. Bioactivities of Geranium wallichianum leaf extracts conjugated with zinc oxide nanoparticles. Biomolecules 2019, 10, 38. [Google Scholar] [CrossRef]
- Bekele, B.; Degefa, A.; Tesgera, F.; Jule, L.T.; Shanmugam, R.; Priyanka Dwarampudi, L.; Nagaprasad, N.; Ramasamy, K. Green versus chemical precipitation methods of preparing zinc oxide nanoparticles and investigation of antimicrobial properties. J. Nanomater. 2021, 2021, 9210817. [Google Scholar] [CrossRef]
- Bulcha, B.; Leta Tesfaye, J.; Anatol, D.; Shanmugam, R.; Dwarampudi, L.P.; Nagaprasad, N.; Bhargavi, V.N.; Krishnaraj, R. Synthesis of zinc oxide nanoparticles by hydrothermal methods and spectroscopic investigation of ultraviolet radiation protective properties. J. Nanomater. 2021, 2021, 8617290. [Google Scholar] [CrossRef]
- Safawo, T.; Sandeep, B.V.; Pola, S.; Tadesse, A. Synthesis and characterization of zinc oxide nanoparticles using tuber extract of anchote (Coccinia abyssinica (Lam.) Cong.) for antimicrobial and antioxidant activity assessment. OpenNano 2018, 3, 56–63. [Google Scholar] [CrossRef]
- Liu, L.; Xu, J.; Wang, D.; Jiang, M.; Wang, S.; Li, B.; Zhang, Z.; Zhao, D.; Shan, C.X.; Yao, B.; et al. p-Type conductivity in n-doped ZnO: The role of the NZn − VO complex. Phys. Rev. Lett. 2012, 108, 215501. [Google Scholar] [CrossRef] [PubMed]
- Hoseinzadeh, A.; Habibi-Yangjeh, A.; Davari, M. Antifungal activity of magnetically separable Fe3O4/ZnO/AgBr nanocomposites prepared by a facile microwave-assisted method. Prog. Nat. Sci. Mater. Int. 2016, 26, 334–340. [Google Scholar] [CrossRef]
- Omar, K.; Meena, B.I.; Muhammed, S.A. Study on the activity of ZnO-SnO2 nanocomposite against bacteria and fungi. Physicochem. Probl. Miner. Process. 2016, 52, 754–766. [Google Scholar]
- Thaya, R.; Malaikozhundan, B.; Vijayakumar, S.; Sivakamavalli, J.; Jeyasekar, R.; Shanthi, S.; Vaseeharan, B.; Ramasamy, P.; Sonawane, A. Chitosan coated Ag/ZnO nanocomposite and their antibiofilm, antifungal and cytotoxic effects on murine macrophages. Microb. Pathog. 2016, 100, 124–132. [Google Scholar] [CrossRef]
- Nguyen, V.T.; Vu, V.T.; Nguyen, T.A.; Tran, V.K.; Nguyen-Tri, P. Antibacterial activity of TiO2-and ZnO-decorated with silver nanoparticles. J. Compos. Sci. 2019, 3, 61. [Google Scholar] [CrossRef]
- Iqbal, J.; Abbasi, B.A.; Yaseen, T.; Zahra, S.A.; Shahbaz, A.; Shah, S.A.; Uddin, S.; Ma, X.; Raouf, B.; Kanwal, S.; et al. Green synthesis of zinc oxide nanoparticles using Elaeagnus angustifolia L. leaf extracts and their multiple in vitro biological applications. Sci. Rep. 2021, 11, 20988. [Google Scholar] [CrossRef]
- Pereira, L.; Dias, N.; Carvalho, J.; Fernandes, S.; Santos, C.; Lima, N. Synthesis, characterization, and antifungal activity of chemically and fungal-produced silver nanoparticles against Trichophyton rubrum. J. Appl. Microbiol. 2014, 117, 1601–1613. [Google Scholar] [CrossRef]
- Kamal, A.; Saba, M.; Kamal, A.; Batool, M.; Asif, M.; Al-Mohaimeed, A.M.; Al Farraj, D.A.; Habib, D.; Ahmad, S. Bioinspired Green Synthesis of Bimetallic Iron and Zinc Oxide Nanoparticles Using Mushroom Extract and Use against Aspergillus niger; The Most Devastating Fungi of the Green World. Catalysts 2023, 13, 400. [Google Scholar] [CrossRef]
- Huang, P.-C.; Tsai, Z.-M.; Lin, K.-Y.; Wang, H. A High-Efficiency, Broadband CMOS Power Amplifier for Cognitive Radio Applications. IEEE Trans. Microw. Theory Tech. 2010, 58, 3556–3565. [Google Scholar] [CrossRef]
- Hayat, S.; Ashraf, A.; Zubair, M.; Aslam, B.; Siddique, M.H.; Khurshid, M.; Saqalein, M.; Khan, A.M.; Almatroudi, A.; Naeem, Z.; et al. Biofabrication of ZnO nanoparticles using Acacia arabica leaf extract and their antibiofilm and antioxidant potential against foodborne pathogens. PloS ONE 2022, 17, e0259190. [Google Scholar] [CrossRef] [PubMed]
- Dehghani, S.; Peighambardoust, S.H.; Peighambardoust, S.J.; Hosseini, S.V.; Regenstein, J.M. Improved mechanical and antibacterial properties of active LDPE films prepared with combination of Ag, ZnO and CuO nanoparticles. Food Packag. Shelf Life 2019, 22, 100391. [Google Scholar] [CrossRef]
- Yang, F.; Song, L.; Xu, Y. C-Band 30 W High PAE Power Amplifier MMIC with Second Harmonic Suppression for Radar Network Application. Micromachines 2022, 13, 2079. [Google Scholar] [CrossRef] [PubMed]

| pH | Bacterial Pathogens | Inhibition Zones Observed at Different Concentrations (mm ± SD) | Standard (Clindamycin) | ||
|---|---|---|---|---|---|
| 5 µg/mL | 10 µg/mL | 15 µg/mL | |||
| 5 | Streptococcus pyogenes | 10.33 ± 0.57 | 11.66 ± 0.57 | 13.33 ± 0.57 | 18.00 ± 0.54 |
| Staphylococcus aureus | 12.62 ± 1.15 | 14.66 ± 0.57 | 16.66 ± 0.57 | 19.01 ± 0.54 | |
| Klebsiella pneumonia | 8.33 ± 0.47 | 8.66 ± 0.47 | 10.33 ± 0.48 | 17.02 ± 0.57 | |
| 9 | Streptococcus pyogenes | 12.60 ± 0.57 | 14.60 ± 0.58 | 16.60 ± 0.59 | 18.22 ± 0.54 |
| Staphylococcus aureus | 16.33 ± 0.57 | 18.66 ± 0.59 | 20.88 ± 0.79 | 19.11 ± 0.54 | |
| Klebsiella pneumonia | 8.66 ± 0.47 | 10.33 ± 0.47 | 12.66 ± 0.47 | 17.33 ± 0.57 | |
| S. No | Type of Nanoparticles | Source | Antimicrobial Potential | Reference |
|---|---|---|---|---|
| 1. | MB-ZnO NPs | Plants | 60% | Huang, P., et al., 2020 [41] |
| 2. | ZnO NPs | Mushroom | 70% | Hayat et al., 2022 [42] |
| 3. | ZnO NPs | Chemical synthesized | 76% | Dehghani et al., 2019 [43] |
| 4. | Zeolite/ZnO | Physiochemical method | 87% | Yang et al., 2022 [44] |
| 5. | ZnO | Plant extract | 80% (antifungal) | Current work |
| 6. | ZnO | Plant extract | 82% (Antileishmanial) | Current work |
| Conc. (ug/mL) | Promastigote Inhibition | Amastigote | IC50 (ug/mL) | IC50 (ug/mL) |
|---|---|---|---|---|
| 400 | 82.40 | 75.15 | 270 Amastigote | 220 Promastigote |
| 200 | 69.90 | 63.00 | ||
| 100 | 57.13 | 54.22 | ||
| 50 | 41.20 | 38.20 |
Disclaimer/Publisher’s Note: The statements, opinions and data contained in all publications are solely those of the individual author(s) and contributor(s) and not of MDPI and/or the editor(s). MDPI and/or the editor(s) disclaim responsibility for any injury to people or property resulting from any ideas, methods, instructions or products referred to in the content. |
© 2023 by the authors. Licensee MDPI, Basel, Switzerland. This article is an open access article distributed under the terms and conditions of the Creative Commons Attribution (CC BY) license (https://creativecommons.org/licenses/by/4.0/).
Share and Cite
Arif, H.; Qayyum, S.; Akhtar, W.; Fatima, I.; Kayani, W.K.; Rahman, K.U.; Al-Onazi, W.A.; Al-Mohaimeed, A.M.; Bangash, N.K.; Ashraf, N.; et al. Synthesis and Characterization of Zinc Oxide Nanoparticles at Different pH Values from Clinopodium vulgare L. and Their Assessment as an Antimicrobial Agent and Biomedical Application. Micromachines 2023, 14, 1285. https://doi.org/10.3390/mi14071285
Arif H, Qayyum S, Akhtar W, Fatima I, Kayani WK, Rahman KU, Al-Onazi WA, Al-Mohaimeed AM, Bangash NK, Ashraf N, et al. Synthesis and Characterization of Zinc Oxide Nanoparticles at Different pH Values from Clinopodium vulgare L. and Their Assessment as an Antimicrobial Agent and Biomedical Application. Micromachines. 2023; 14(7):1285. https://doi.org/10.3390/mi14071285
Chicago/Turabian StyleArif, Hajira, Sidra Qayyum, Wasim Akhtar, Iram Fatima, Waqas Khan Kayani, Khursheed Ur Rahman, Wedad A. Al-Onazi, Amal M. Al-Mohaimeed, Naila Khan Bangash, Nasra Ashraf, and et al. 2023. "Synthesis and Characterization of Zinc Oxide Nanoparticles at Different pH Values from Clinopodium vulgare L. and Their Assessment as an Antimicrobial Agent and Biomedical Application" Micromachines 14, no. 7: 1285. https://doi.org/10.3390/mi14071285
APA StyleArif, H., Qayyum, S., Akhtar, W., Fatima, I., Kayani, W. K., Rahman, K. U., Al-Onazi, W. A., Al-Mohaimeed, A. M., Bangash, N. K., Ashraf, N., Razak, S. A., Kamal, A., & Ali, S. (2023). Synthesis and Characterization of Zinc Oxide Nanoparticles at Different pH Values from Clinopodium vulgare L. and Their Assessment as an Antimicrobial Agent and Biomedical Application. Micromachines, 14(7), 1285. https://doi.org/10.3390/mi14071285

